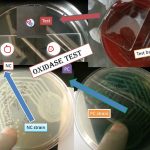
Oxidase test

Tag: Oxidase test
Proteus mirabilis- Introduction, Morphology, Pathogenicity, Lab Diagnosis, Treatment, Prevention, and Keynotes
 Introduction Proteus mirabilis is a Gram-negative bacterium known for its...
Introduction Proteus mirabilis is a Gram-negative bacterium known for its...
Oxidase Test: Principle, Procedure, Result Interpretation and Various Oxidase Positive Organisms
Introduction of Oxidase Test (Kovac's Method) Gordon and McLeod introduced...
Introduction of Oxidase Test (Kovac's Method) Gordon and McLeod introduced...
